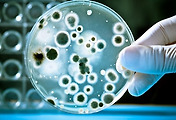

옻 올랐을때 처치법, 증상
옻나무는 사실 원산지가 히말라야 부근으로 한반도에 자생하던 나무는 아니다.
하지만 이런 옻나무에서 나오는 수액이 가구를 칠 할때 좋은 도료로 사용되었기 때문에 필요에 의해 한반도로 들여오게 되었는데,
이런 "옻칠"을 한 가구는 외부의 오염으로부터 가구를 보호하여 방충, 내열, 내수성을 갖게 해줘 보존성이 극도로 올라가게 된다.
우리 말에 "칠흑같은 어둠"이라는 표현에서의 "칠흑"이 바로 이 옻칠을 한 가구의 색깔을 말하는 것이다.
옻독
문제는 이 옻나무에 독성이 있다는 것이다.
옻나무에 있는 우루시올이라는 성분은 공기에 접촉하면 굳는 성분으로 옻칠을 하는데 있어 핵심적인 역할을 담당하지만
이것이 피부에 접촉할 경우 체내 림프관을 타고 전신으로 퍼지면서 피부 트러블을 일으킨다.
옻 올랐을 때 증상
옻독이 오르게 되면 강한 가려움을 느끼게 된다. 동시에 전신에 알레르기성 두드러기가 발생한다. 이는 며칠 정도가 지나면 곧 잦아들지만, 두드러기를 긁는다거나 옻독에 약한 체질이라면 오래 갈 수도 있다.
피부과에서는 다량의 부신피질호르몬제와 항히스타민제로 1~3주의 치료 내지 심할 경우 입원이 권장될 수 있다.

이 때문에 옻 수액을 다루는 장인들은 옻과 접촉 가능성이 높은 손이나 다른 피부에 기름을 바르는 식으로 옻이 신체로 흡수되지 않게 막고 작업을 한다. 만약 이러고도 옻독이 오르면 우선 옻독이 오른 부위를 깨끗이 씻고 고운 소금물을 환부에 바르면 가려움증이 완화가 된다고 한다.
 <옻나무 모습>
<옻나무 모습>옻의 효능
하지만 옻에는 항균, 항암 성분이 많이 들어있어 섭취를 할 경우 건강에 도움이 된다. 문제가 되는 우루시올 성분도 고온으로 조리될 경우 그 성분이 약해지기 때문에 잘 조리해서 먹을 경우 큰 문제를 일으키는 경우가 적다. 일부 식당에서는 옻독 방지용 약을 같이 제공하는 경우도 많은데, 대표적으로 "옻닭"이 있다.
옻닭은 옻을 넣고 우려낸 닭곰탕으로 대표적인 옻 음식이다. 이 옻닭을 제공하는 식당에서는 옻닭과 함께 옻독 방지용 약을 함께 제공하기도 한다.
그리고 옻닭을 집에서 직접 조리할 때는 절대로 김을 쐬서는 안 된다. 우루시올이 휘발성이기 때문에 김과 함께 빠져나오기 때문이다.

'건강정보' 카테고리의 다른 글
| 과산화수소 만이 정답일까? 차세대 상처 소독약 (0) | 2017.05.26 |
|---|---|
| 몸살 빨리 낫는 법 (0) | 2017.05.24 |
| 물파스 효능, 모기 물린 데 바르는 건 효과 있을까? (0) | 2017.05.19 |
| 기침 멈추는 법 (0) | 2017.05.18 |
| 후시딘 마데카솔 효과 및 차이점 (0) | 2017.05.15 |

댓글